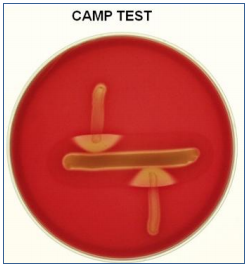
Enunciado 1130931-1

O texto abaixo servirá de base para a questão.
O perigo da inteligência artificial para a humanidade
Rafael Ciscati e Marcos Coronato
Na ficção científica, a inteligência artificial, ou I.A., tem alguns papéis recorrentes. Costuma
brilhar como a antagonista que pretende exterminar a humanidade. Esse é o propósito da Skynet,
a versão militar e maligna da internet, no filme O exterminador do futuro: gênesis, a estrear em
2015. Nos últimos meses, os perigos da I.A. vêm sendo discutidos mais seria mente por gente
brilhante como o astrofísico Stephen Hawking e o empresário Elon Musk, atuante nos setores
de carros elétricos e exploração espacial. Porém, poucos atentaram à ideia central do pensador
que desencadeou a discussão. O filósofo sueco Nick Bostrom não teme que as I.A’s. detestem
pessoas ou que tentem machucá-las e afirma que “essas máquinas serão indiferentes a nós”.
Formas de I.A. indiferentes à humanidade ou com estratégias incompreensíveis por nós
poderiam causar destruição física e caos social ao controlar bancos de dados, mercados
financeiros, infraestrutura, redes de distribuição e sistemas de armamentos. Bostrom,
pesquisador na Universidade de Oxford, no Reino Unido, dirige o Instituto para o Futuro da
Humanidade. Pesquisa riscos existenciais à vida humana, como a colisão de asteroides com a
Terra. O surgimento da I.A. e seus perigos ocupam seu livro mais recente, Superintelligence
(Superinteligência, ainda sem previsão de lançamento no Brasil). Bostrom alerta para o advento
de sistemas não só inteligentes, mas capazes de se autoaprimorar. Um computador assim
poderia se reprogramar para elevar sua própria capacidade. Mais poderoso, poderia fazer isso de
novo, e de novo. Desenvolveria, assim, capacidades de observação, aprendizado e planejamento
muito superiores à humana. Bostrom chama esse fenômeno de superinteligência e conclui que
ele é o principal risco existencial visível no futuro da humanidade. “Não devemos acreditar que
o cérebro humano poderá competir com isso”, diz.
O filósofo acredita que o surgimento de tecnologia assim não é questão de “se”, e sim de
“quando”. Em 2012 e 2013, ele fez um levantamento de opinião a respeito com 170 especialistas.
Na média, eles estimaram em 50% a chance de surgir, até 2050, uma I.A. capaz de assumir a
maior parte das profissões humanas e em 90% a chance de isso ocorrer até 2075. Mais da
metade dos entrevistados previu que a superinteligência emergiria até 30 anos depois e que
haverá 33% de chance de ela ser algo “ruim” ou “extremamente ruim”.
As preocupações se amparam na aceleração da evolução na área. Bart Selman,
matemático da Universidade Cornell, estuda I.A. desde os anos 1980 e se impressiona com os
avanços dos últimos cinco anos. Carros autônomos, software de tradução simultânea e de
reconhecimento de imagem usam avanços obtidos com I.A. Conforme surgem aplicações
comerciais, mais dinheiro flui para esse tipo de pesquisa, o que a acelera. Novas fronteiras de
estudo, como as redes neurais artificiais e os chips neuromórficos, abrem frentes promissoras na
tentativa de reproduzir o jeito humano de pensar.
Nada garante, porém, que uma superinteligência – uma inteligência capaz de aprimorar a si
mesma – continuará a pensar imitando o jeito humano, ou de forma que seja previsível ou
compreensível por nós. Diante dessa possibilidade, homens inteligentes reagiram com
superlativos. Musk comparou o ato de criar I.A. com invocar o demônio. Hawking afirmou que o
advento da I.A. será o maior evento da história humana. “Infelizmente, poderia também ser o
último, a não ser que aprendamos a evitar os riscos”, disse. O astrofísico tocou no ponto certo.
Nenhum dos estudiosos imagina interromper o avanço científico. Eles apenas ponderam que,
antes de criar I.A., precisaremos criar regras para que seja seguro usá-la – ou conviver com ela.
Disponível em: <http://epoca.globo.com/ideias/noticia/2015/04/o-perigo-da-inteligencia-artificial-parahumanidade.html>. Acesso em: 2 de ago. 2015. [Adaptado]